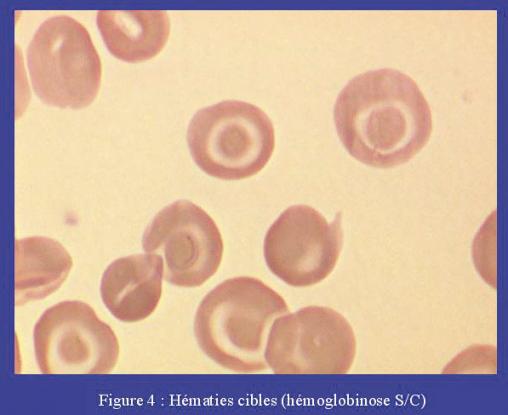

Les cellules cibles sont des globules rouges dont l’enveloppe est trop grande par rapport au contenu en hémoglobine. L’hémoglobine, qui se répartit au centre et à la périphérie du globule rouge, donne alors un aspect en « cellule cible ». Il existe deux principaux mécanismes : diminution de la quantité d’hémoglobine intracellulaire et, beaucoup plus rarement, augmentation de la couche membranaire externe, en relation avec undéficit de l’activité de la lécithine-cholestérol-acyltransférase,ce qui entraîne une augmentation du ratio cholestérol/phospholipides chez les patients ayant une hépatopathie obstructive. En pratique, les hématies cibles orientent surtout vers une hémoglobinopathie : hémoglobinose C, hémoglobinose E et syndromes drépanocytaires S/C, S/bêta-thalassémie